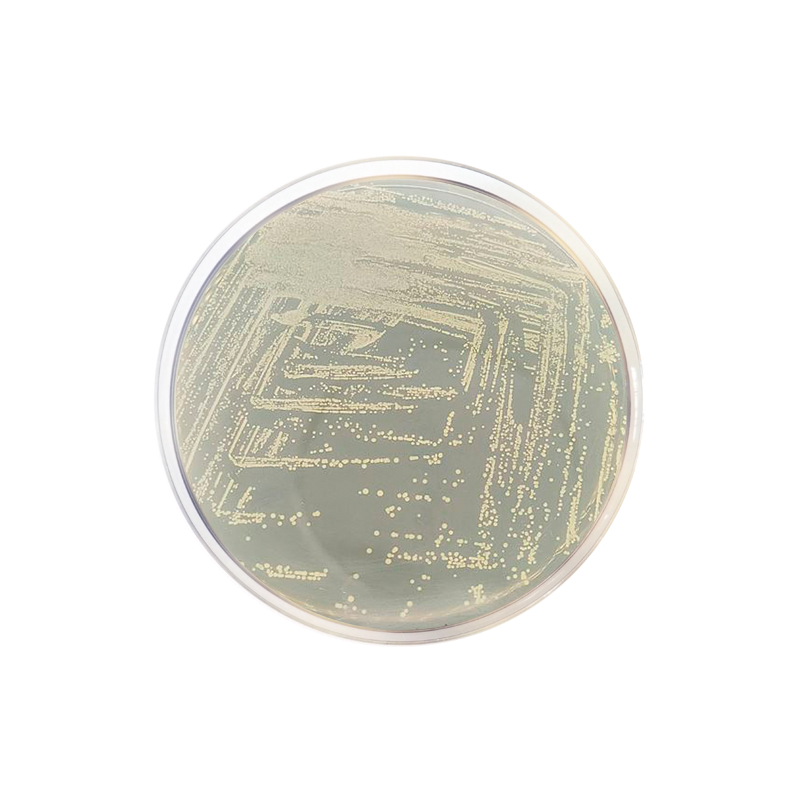
Dextrose Agar Formato 500 g

◆FULL◆ Cestrose Nude 2026 Archive Vids & Pics Fast Access
Get exclusive access to the cestrose nude premium vault released in January 2026. Our platform provides a massive collection of 4K video sets, high-res images, and exclusive media clips. To ensure the best experience, get instant file access with no subscription fees. Experience cestrose nude through high-quality video files. The current media pack features exclusive PPV videos, behind-the-scenes photos, and rare digital files. Get the freshest cestrose nude media drops. Click the download link now to unlock the premium gallery.
Response rates are variable and many treatments pose challenges for patient adherence By blocking these proteins, it reduces esophageal inflammation and alleviates symptoms of eosinophilic esophagitis. Therapies that are easy to administer, regulate underlying type 2 inflammation, and reduce disease progression in eoe are desirable
Michaella's Bread & Pastries - "Beware of deceptive sweeteners
This review focuses on dupilumab, which is the only food and drug administration (fda) approved biologic therapy for eoe. Breakthroughs in biologic therapy for eosinophilic esophagitis biologics and other novel therapies are needed for treatment. Serious side effects can occur
Please see important safety information and prescribing information and patient information on website.
It is approved for eoe in children 1 year and older who weigh at least 15 kg (33 lb) with eoe. While eosinophilic targeting biologic therapy has been successful in eosinophilic asthma, hes, egpa, and crswnp leading to fda approval for these conditions, trials treating eoe and egid have been disappointing to date. This review focuses on biologics therapy in eoe. It is indicated for adult and pediatric patients aged 1 year and older who weigh at least 33 pounds (15 kg).
Dupixent is an injectable biologic medicine Here’s how it helps with eosinophilic esophagitis. The recent approval of dupilumab for treatment of eosinophilic esophagitis (eoe), research into better biomarkers, and the anticipated availability of a metric to assess eoe severity all bode well for patients Speakers considered the ramifications of these developments